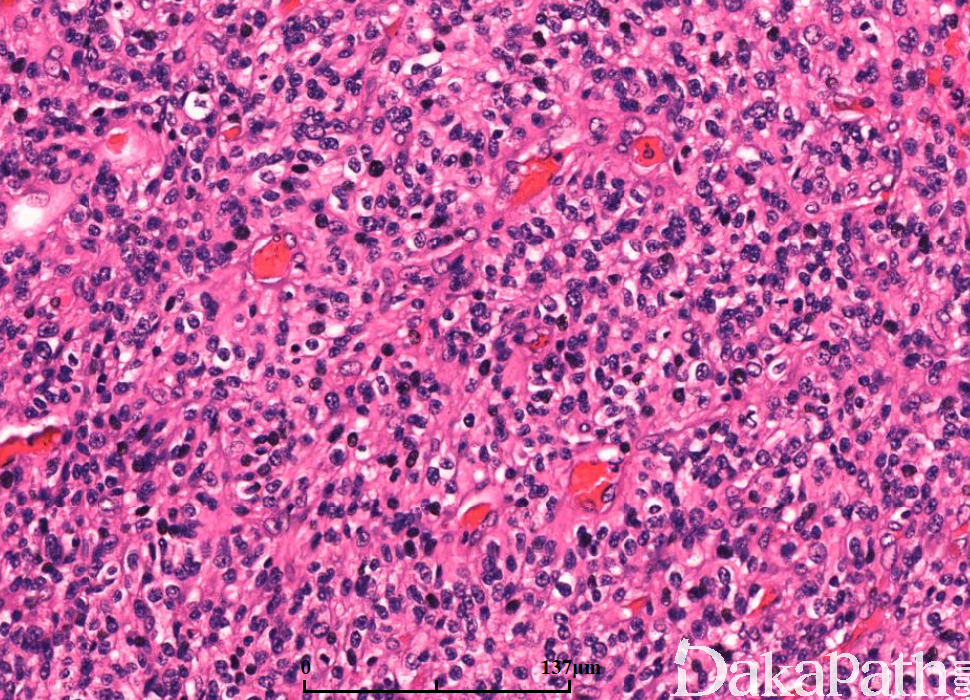

胶质母细胞瘤
Glioblastoma(GBM)
概述:
以星形细胞分化为主的高级别胶质瘤,属于 WHO IV 级。原发性胶质母细胞瘤占所有胶质母细胞瘤的 95%,症状持续 < 3 个月;继发性胶质母细胞瘤占 5%,之前存在相对低级别的星形细胞瘤。
发病部位: 大脑半球、胼胝体、视觉通路、脑干、小脑及脊椎
诊断要点:
最常见的胶质瘤,年龄常> 40 岁,儿童的 GBM 例外,原发性胶质母细胞瘤男性稍增多,而继发性胶质母细胞瘤偏向女性增多。原发性症状较急一般小于 3 个月,继发性呈持续性表现,临床可见癫痫、头痛及疝的形成,根据部位而定的神经功能缺陷。
大体:多数呈广泛浸润脑组织,可见坏死。
病变界限不清,浸润性生长伴继发性改变(神经周围卫星现象、血管周围及软膜下聚集),偶见界限清楚(至少部分,尤其是巨细胞亚型、上皮样、横纹肌样及脑膜受累的任何类型)。
扩散的方式:可见直接局灶受累、室管膜下、脊椎内软脑膜及系统性受累(骨髓、肝脏及淋巴结)。
镜下:可见凝固性坏死伴或无假栅栏状,肾小球样血管增生,多层、腔内内皮细胞增生,小血管血栓形成。
多数小细胞亚型可见核分裂,少数位于治疗后“静止”期的肿瘤。可见凋亡,尤其位于假栅栏状区域。
细胞类型可见纤维性星形细胞、肥胖型星形细胞、中等大多形性星形细胞、小细胞(双极、细胞温和及核分裂活跃)、上皮样(不常见;细胞边界清楚、玻璃样胞浆及圆形空透亮胞核伴核仁可见)、横纹肌样(罕见;边界不清、偏位卵圆形胞核及显著核仁及核旁明显丝状漩涡)、颗粒状(浆内粗糙的溶酶体、胞核温和及类似巨噬细胞)及脂肪样(罕见,类似脂肪组织)。血管周围淋巴细胞浸润(尤其肥胖细胞型)。可见大量 CD68 阳性的小胶质细胞。
肿瘤亚型:常见纤维性及肥胖细胞性星形细胞的混合亚型;小细胞亚型呈小细胞片状增生类似低倍镜下的少突胶质细胞瘤,偶见微钙化及形成不良的血管周假菊形团;巨细胞亚型常很少出现浸润的证据,可见大的、奇异形多核细胞,间质纤维化,部分病例血管周围可见淋巴细胞,少量微血管增生或假栅栏状坏死;GBM 伴少突胶质细胞瘤的成分可见经典型少突胶质细胞瘤灶(常较少),坏死可见;GBM 伴神经元免疫表型无预后意义,亦不是胶质神经元诊断的根据;GBM 伴原始神经外胚层成分常可见局灶富于细胞的 PNET 灶,呈小细胞或大细胞,部分可见神经母细胞性菊形团(Homer Wright 菊形团);GBM 伴间叶分化(胶质肉瘤);GBM 伴上皮分化(多数发生在胶质肉瘤),可见鳞状及或腺样结构;急性坏死伴多核粒细胞,可见急性中性粒细胞浸润,提示细菌脑脓肿形成;梗死可见广泛富于巨噬细胞的坏死。

免疫组织化学染色:
GFAP(+)、AE1/AE3(+)、CAM5.2(-)及 Olig2(+)、Nestine(+)。Mutant IDH1 在继发性胶质母细胞瘤中呈阳性,在原发性胶母呈阴性。上皮化生的肿瘤 EMA(+)及 cytokeratins (+)。横纹肌样胶母 INI1 核表达缺失,常规胶质母细胞瘤 INI1 核表达保留。继发性及巨细胞亚型胶母的 P53 阳性,在原发性不常见。Ki67 在 PNET 样成分中阳性指数较高。部分病例巨噬细胞标记 CD68。
鉴别诊断:
间变型少突胶质细胞瘤 :细胞形态单一,核呈圆形,常与 II 级少突胶质细胞瘤相关,1p/19q 共同缺失。
间变型室管膜细胞瘤 :局灶可见浸润,形态单一,血管周围假菊形团,真正菊形团不常见,微管点状 EMA 阳性,菊形团表面 EMA 阳性。
转移性肿瘤 :边界尚清,可见上皮或黑色素特征,无血管增生的特点(肾脏除外),上皮或黑色素标记阳性,邻近脑组织的外周血管、淋巴管浸润。
原发性 CNS 淋巴瘤 :血管中心性,导致淋巴瘤细胞片状分布,细胞胞核圆形或不规则,核仁显著及胞浆稀少,可见大量凋亡,无血管增生。
髓母细胞瘤(小脑) :结节-促结缔组织增生可见结节及网状蛋白,少许或无胶质分化,Synaptophysin 阳性,坏死不常见,常无假栅栏状,微血管增生罕见。
原始神经外胚叶肿瘤(幕上) :Synaptophysin 阳性,部分病例可见结节状结构。
急性/亚急性梗死 :血管细胞肥厚(最低限度的增生),亚急性及慢性阶段可见巨噬细胞。
脓肿 :无恶性细胞,呈急性炎症,显著的淋巴浆细胞浸润,机化组织中纤维母细胞增生或囊性改变。
